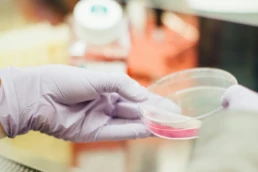

Our Private Drug and Alcohol Testing Services
Urine Testing
Urine testing is a widely used method to detect the presence of drugs and their metabolites in the body. This non-invasive test provides a comprehensive overview of recent drug use and is suitable for a variety of substances. We utilize the gold standard 5-Panel test, although a more comprehensive or drug specific test can be provided if needed.
Fluid Testing
Our oral/fluid testing is a convenient alternative to traditional urine testing. This method analyzes saliva to detect the presence of drugs, offering a shorter detection window for some substances.
Urine and Breath Alcohol Testing
For those requiring alcohol testing, our urine and breath alcohol testing provides quick and accurate results. This POCT method and breathalyzer are ideal for assessing current alcohol intoxication levels and are commonly used in workplace settings and legal situations.
Hair Strand often called hair follicle: During this t
Hair Strand Often Called Hair Follicle:
During this test, a small amount of hair is removed and tested.

Lab-Based vs. Non-Lab Based Private Drug Testing
Lab-Based Testing
Detection Window: Lab-based tests may have a longer detection window, capturing a more extended period of drug use.
Comprehensive Analysis: This method allows for a more comprehensive analysis and review of substances, making it suitable for collecting detailed and specific drug testing results.
Non-Lab Based Testing
Speed: Non-lab based testing provides rapid results, often within minutes, making it ideal for situations that require immediate feedback.
Convenience: These tests are generally more convenient and can be conducted on-site, reducing the time and effort involved in the testing process.
Cost-Effective: Non-lab based testing is often more cost-effective, making it a practical choice for routine or on-demand testing needs.
On-Demand Testing
At Pacific Interventions, we understand that the need for drug testing can arise at any time. That’s why we offer on-demand testing services, allowing you to schedule tests at your convenience.
Whether it’s for personal reasons, family peace of mind, or legal requirements, our flexible scheduling ensures you have access to timely and reliable testing services.
Why Choose Pacific Interventions?
Choose Pacific Interventions for reliable, confidential, and on-demand personal drug and alcohol testing services. Contact us today to schedule your test or inquire about our comprehensive testing options.
Confidentiality
Your privacy is our priority. All testing is conducted with the utmost confidentiality and compliance with privacy regulations.
Accurate Results
We use state-of-the-art testing methods to provide accurate and reliable results.
Professional Staff
Our team of experienced professionals ensures that the testing process is conducted with precision and care.
On-Demand Testing
We make it easy for you to access our services conveniently, with our mobile testing services, we come to you. If preferred we can also set up times to meet at our office.
Common Drugs Tested But Not Limited To
- Benzodiazepines
- Alcohol/Ethanol
- Amphetamines
- Barbiturates
- Fentanyl
- Cocaine
- Methamphetamines
- Phencyclidine
- Propoxyphene
- Methadone
- Suboxone
- Opiates


Private Drug Testing (POCT)
When you need answers immediately, our POCT will be the best option. Pacific Interventions & Recovery Solutions provides various panel private drug and alcohol testing depending on your specific need. This type of urinalysis test reveals what drugs are currently in the persons system. Unlike lab based tests, the amount of each substance is not measured. Adulteration strips are used to ensure the correct PH balance, creatine levels, and that no foreign elements have been added to the test. Your results will be accurate and reliable!
FAQ's
Private Drug Testing
Answers to frequently asked questions about private drug testing.
Private drug and alcohol testing is a confidential service that screens individuals for substance use using medically accepted methods. It can be used for personal peace of mind, workplace compliance, legal requirements, or as part of an intervention or treatment planning process.
These tests are commonly requested by individuals concerned about their own substance use, employers and HR departments for workplace safety, families during an intervention, or legal representatives needing objective evidence for court‑related matters.
Private testing panels can screen for alcohol and a wide range of substances, including but not limited to opioids, benzodiazepines, amphetamines, cocaine, cannabis, and prescription medications. Specific panels vary based on needs and can be customised.
Testing may involve urine, saliva, hair, or blood samples, depending on the substance being tested and the detection window required. All samples are processed using reliable analytical methods to ensure accuracy and confidentiality.
Yes. Private drug and alcohol testing services provided through Pacific Interventions are conducted with strict confidentiality. Results are shared only with the individual tested or an authorised party, depending on consent.
Turnaround times vary by test type and laboratory processing. Some rapid alcohol screenings and preliminary drug tests may return results immediately, while comprehensive laboratory drug panels typically take 24–72 hours.
Yes. Private testing is often integrated into broader care plans, intervention planning, and treatment assessment to provide objective data that supports clinical decisions and progress monitoring.
When performed by accredited laboratories and properly documented, private drug and alcohol test results can be accepted for legal or employment purposes, depending on jurisdiction and specific requirements.
Tests can be scheduled by contacting Pacific Interventions directly. A trained representative will explain options, arrange appointments, and walk you through consent and preparation steps.
Private testing offers enhanced confidentiality, personalised service, flexible scheduling, and the ability to select custom panels that match specific needs. It also supports early detection and informed decision‑making without the formal constraints of employer‑mandated programs.